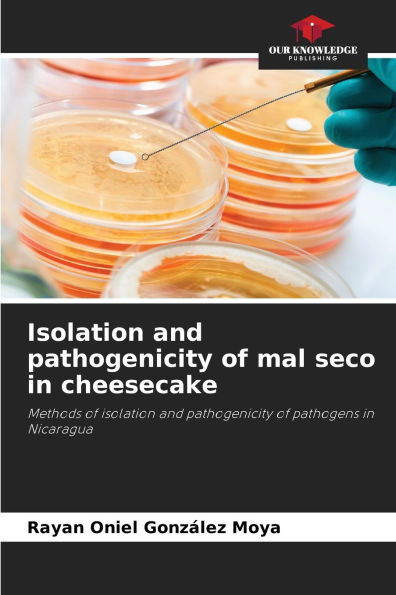
Isolation and pathogenicity of mal seco in cheesecake

Home
A Song of Isolation
Barnes and Noble
Loading Inventory...
A Song of Isolation in Chattanooga, TN
Current price: $35.69

Barnes and Noble
A Song of Isolation in Chattanooga, TN
Current price: $35.69
Loading Inventory...
Size: Audiobook
In this breathtakingly brutal and intensely topical psychological thriller, a man is accused of child sexual abuse, and his life and that of his actress girlfriend are thrown into turmoil…
‘Malone is the master of twists, turns and the unexpected, with the skill to keep things grounded. So much so, that the reader can picture themselves in the very circumstances described. Superb storytelling from a master of his craft’
Herald Scotland
‘Beautiful, lyrical prose takes the reader through a perfectly constructed, often harrowing tale’
Denzil Meyrick
_________________
Film star Amelie Hart is the darling of the silver screen, appearing on the front pages of every newspaper. But at the peak of her fame she throws it all away for a regular guy with an ordinary job. The gossip columns are aghast: what happened to the woman who turned heads wherever she went?
Any hope the furore will die down are crushed when Amelie’s boyfriend Dave is arrested on charges of child sexual abuse. Dave strongly asserts his innocence, and when Amelie refuses to denounce him, the press witch hunt quickly turns into physical violence, and she has to flee the country.
While Dave is locked up with the most depraved men in the country and Amelie is hiding on the continent, Damaris, the victim at the centre of the story, is isolated – a child trying to make sense of an adult world.
Breathtakingly brutal, dark and immensely moving,
A Song of Isolation
looks beneath the magpie glimmer of celebrity to uncover a sinister world dominated by greed and lies, and the unfathomable destruction of innocent lives … in an instant.
Praise for Michael J. Malone
‘A beautifully written tale, original, engrossing and scary … a dark joy’
The Times
‘A complex and multilayered story – perfect for a wintry night’
Sunday Express
‘Vivid, visceral and compulsive’
Ian Rankin
‘A terrific read … I read it in one sitting’
Martina Cole
‘A deeply satisfying read’
Sunday Times
‘A fine, page-turning thriller’
Daily Mail
‘With each turn of the page, a more shocking detail is revealed and some of the people John thought might help him are not who they seem … The domestic noir tale is one that many families will be able to relate to … There is barely enough time to catch your’
Scotsman
‘Challenging and emotional … enthrals as it corkscrews to a shocking, yet ultimately rewarding end’
LoveReading
‘Malone’s latest is an unsettling, multi-layered and expertly paced domestic noir drama that delves into one family’s dark secrets, shame and lies’
CultureFly
‘Malone is a poet, there are wonderful lyrical passages here and very skilful storytelling. Some issues are not spoken about enough, Malone raises a couple of those issues and sensitively but realistically addresses them…’
New Books Magazine
‘Engrossing, hard-hitting – even shocking – with a light poetic frosting. Another superb read!’
Douglas Skelton
'A dark and unnerving psychological thriller that draws you deep into the lives of the characters and refuses to let go. This is a brilliantly written book; I could not put it down’
Caroline Mitchell
‘A chilling tale of the unexpected that journeys right into the dark heart of domesticity’
Marnie Riches
‘Malone is the master of twists, turns and the unexpected, with the skill to keep things grounded. So much so, that the reader can picture themselves in the very circumstances described. Superb storytelling from a master of his craft’
Herald Scotland
‘Beautiful, lyrical prose takes the reader through a perfectly constructed, often harrowing tale’
Denzil Meyrick
_________________
Film star Amelie Hart is the darling of the silver screen, appearing on the front pages of every newspaper. But at the peak of her fame she throws it all away for a regular guy with an ordinary job. The gossip columns are aghast: what happened to the woman who turned heads wherever she went?
Any hope the furore will die down are crushed when Amelie’s boyfriend Dave is arrested on charges of child sexual abuse. Dave strongly asserts his innocence, and when Amelie refuses to denounce him, the press witch hunt quickly turns into physical violence, and she has to flee the country.
While Dave is locked up with the most depraved men in the country and Amelie is hiding on the continent, Damaris, the victim at the centre of the story, is isolated – a child trying to make sense of an adult world.
Breathtakingly brutal, dark and immensely moving,
A Song of Isolation
looks beneath the magpie glimmer of celebrity to uncover a sinister world dominated by greed and lies, and the unfathomable destruction of innocent lives … in an instant.
Praise for Michael J. Malone
‘A beautifully written tale, original, engrossing and scary … a dark joy’
The Times
‘A complex and multilayered story – perfect for a wintry night’
Sunday Express
‘Vivid, visceral and compulsive’
Ian Rankin
‘A terrific read … I read it in one sitting’
Martina Cole
‘A deeply satisfying read’
Sunday Times
‘A fine, page-turning thriller’
Daily Mail
‘With each turn of the page, a more shocking detail is revealed and some of the people John thought might help him are not who they seem … The domestic noir tale is one that many families will be able to relate to … There is barely enough time to catch your’
Scotsman
‘Challenging and emotional … enthrals as it corkscrews to a shocking, yet ultimately rewarding end’
LoveReading
‘Malone’s latest is an unsettling, multi-layered and expertly paced domestic noir drama that delves into one family’s dark secrets, shame and lies’
CultureFly
‘Malone is a poet, there are wonderful lyrical passages here and very skilful storytelling. Some issues are not spoken about enough, Malone raises a couple of those issues and sensitively but realistically addresses them…’
New Books Magazine
‘Engrossing, hard-hitting – even shocking – with a light poetic frosting. Another superb read!’
Douglas Skelton
'A dark and unnerving psychological thriller that draws you deep into the lives of the characters and refuses to let go. This is a brilliantly written book; I could not put it down’
Caroline Mitchell
‘A chilling tale of the unexpected that journeys right into the dark heart of domesticity’
Marnie Riches
In this breathtakingly brutal and intensely topical psychological thriller, a man is accused of child sexual abuse, and his life and that of his actress girlfriend are thrown into turmoil…
‘Malone is the master of twists, turns and the unexpected, with the skill to keep things grounded. So much so, that the reader can picture themselves in the very circumstances described. Superb storytelling from a master of his craft’
Herald Scotland
‘Beautiful, lyrical prose takes the reader through a perfectly constructed, often harrowing tale’
Denzil Meyrick
_________________
Film star Amelie Hart is the darling of the silver screen, appearing on the front pages of every newspaper. But at the peak of her fame she throws it all away for a regular guy with an ordinary job. The gossip columns are aghast: what happened to the woman who turned heads wherever she went?
Any hope the furore will die down are crushed when Amelie’s boyfriend Dave is arrested on charges of child sexual abuse. Dave strongly asserts his innocence, and when Amelie refuses to denounce him, the press witch hunt quickly turns into physical violence, and she has to flee the country.
While Dave is locked up with the most depraved men in the country and Amelie is hiding on the continent, Damaris, the victim at the centre of the story, is isolated – a child trying to make sense of an adult world.
Breathtakingly brutal, dark and immensely moving,
A Song of Isolation
looks beneath the magpie glimmer of celebrity to uncover a sinister world dominated by greed and lies, and the unfathomable destruction of innocent lives … in an instant.
Praise for Michael J. Malone
‘A beautifully written tale, original, engrossing and scary … a dark joy’
The Times
‘A complex and multilayered story – perfect for a wintry night’
Sunday Express
‘Vivid, visceral and compulsive’
Ian Rankin
‘A terrific read … I read it in one sitting’
Martina Cole
‘A deeply satisfying read’
Sunday Times
‘A fine, page-turning thriller’
Daily Mail
‘With each turn of the page, a more shocking detail is revealed and some of the people John thought might help him are not who they seem … The domestic noir tale is one that many families will be able to relate to … There is barely enough time to catch your’
Scotsman
‘Challenging and emotional … enthrals as it corkscrews to a shocking, yet ultimately rewarding end’
LoveReading
‘Malone’s latest is an unsettling, multi-layered and expertly paced domestic noir drama that delves into one family’s dark secrets, shame and lies’
CultureFly
‘Malone is a poet, there are wonderful lyrical passages here and very skilful storytelling. Some issues are not spoken about enough, Malone raises a couple of those issues and sensitively but realistically addresses them…’
New Books Magazine
‘Engrossing, hard-hitting – even shocking – with a light poetic frosting. Another superb read!’
Douglas Skelton
'A dark and unnerving psychological thriller that draws you deep into the lives of the characters and refuses to let go. This is a brilliantly written book; I could not put it down’
Caroline Mitchell
‘A chilling tale of the unexpected that journeys right into the dark heart of domesticity’
Marnie Riches
‘Malone is the master of twists, turns and the unexpected, with the skill to keep things grounded. So much so, that the reader can picture themselves in the very circumstances described. Superb storytelling from a master of his craft’
Herald Scotland
‘Beautiful, lyrical prose takes the reader through a perfectly constructed, often harrowing tale’
Denzil Meyrick
_________________
Film star Amelie Hart is the darling of the silver screen, appearing on the front pages of every newspaper. But at the peak of her fame she throws it all away for a regular guy with an ordinary job. The gossip columns are aghast: what happened to the woman who turned heads wherever she went?
Any hope the furore will die down are crushed when Amelie’s boyfriend Dave is arrested on charges of child sexual abuse. Dave strongly asserts his innocence, and when Amelie refuses to denounce him, the press witch hunt quickly turns into physical violence, and she has to flee the country.
While Dave is locked up with the most depraved men in the country and Amelie is hiding on the continent, Damaris, the victim at the centre of the story, is isolated – a child trying to make sense of an adult world.
Breathtakingly brutal, dark and immensely moving,
A Song of Isolation
looks beneath the magpie glimmer of celebrity to uncover a sinister world dominated by greed and lies, and the unfathomable destruction of innocent lives … in an instant.
Praise for Michael J. Malone
‘A beautifully written tale, original, engrossing and scary … a dark joy’
The Times
‘A complex and multilayered story – perfect for a wintry night’
Sunday Express
‘Vivid, visceral and compulsive’
Ian Rankin
‘A terrific read … I read it in one sitting’
Martina Cole
‘A deeply satisfying read’
Sunday Times
‘A fine, page-turning thriller’
Daily Mail
‘With each turn of the page, a more shocking detail is revealed and some of the people John thought might help him are not who they seem … The domestic noir tale is one that many families will be able to relate to … There is barely enough time to catch your’
Scotsman
‘Challenging and emotional … enthrals as it corkscrews to a shocking, yet ultimately rewarding end’
LoveReading
‘Malone’s latest is an unsettling, multi-layered and expertly paced domestic noir drama that delves into one family’s dark secrets, shame and lies’
CultureFly
‘Malone is a poet, there are wonderful lyrical passages here and very skilful storytelling. Some issues are not spoken about enough, Malone raises a couple of those issues and sensitively but realistically addresses them…’
New Books Magazine
‘Engrossing, hard-hitting – even shocking – with a light poetic frosting. Another superb read!’
Douglas Skelton
'A dark and unnerving psychological thriller that draws you deep into the lives of the characters and refuses to let go. This is a brilliantly written book; I could not put it down’
Caroline Mitchell
‘A chilling tale of the unexpected that journeys right into the dark heart of domesticity’
Marnie Riches
![Songs For A Nervous Planet [Blue Raspberry Cream 2 LP] [Barnes & Noble Exclusive]](https://prodimage.images-bn.com/pimages/0888072650992_p0_v2_s600x595.jpg)

![Songs for Distingué Lovers [Yellow Vinyl] [Barnes & Noble Exclusive]](https://prodimage.images-bn.com/pimages/0602458656831_p0_v2_s600x595.jpg)
![Christmas Songs [Opaque Gold Vinyl] [Barnes & Noble Exclusive]](https://prodimage.images-bn.com/pimages/0888072568822_p0_v2_s600x595.jpg)